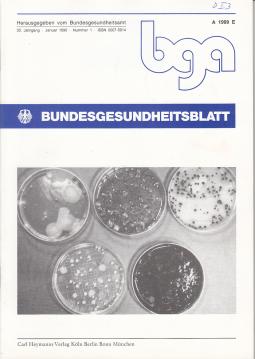
Bundesgesundheitsblatt. 33. Jahrgang (1990) Bundesgesundheitsblatt. 33. Jahrgang (1990)

Bundesgesundheitsblatt. 33. Jahrgang (1990) von Bundesgesundheitsamt (Hrsg)
28311
Deutsch
ISSN 0007-5914
-
gut12 Hefte (Jan-Dez), 628 S. Klammerheftung. Besitzvermerk auf dem Deckel, sonst sauber u. frisch.
Köln, Berlin, Bonn, München: Carl Heymann , 1990
-
-
24.00€
0.00€


